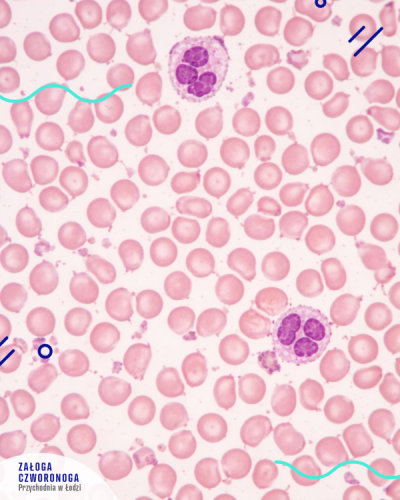

Drogi Kliencie, niniejsza Polityka Prywatności jest dokumentem, który ma charakter informacyjny, abyś mógł poznać obowiązujące na naszej stronie standardy dotyczące przetwarzania danych osobowych.
Z niniejszej Polityki dowiesz się, jakie dane osobowe gromadzimy, w jaki sposób je przetwarzamy oraz jakich zasad przestrzegamy.
Prosimy o zapoznanie się z treścią Polityki Prywatności, zanim skorzystasz z naszej oferty.
W razie wątpliwości lub sprzeczności pomiędzy Polityką a udzielonymi przez daną osobę zgodami niezależnie od postanowień Polityki, zawsze podstawą do podejmowania oraz określenia przez Administratora zakresu działań są dobrowolnie udzielone zgody lub przepisy prawa. W przypadku takiej sprzeczności pomiędzy Polityką a treścią klauzul informacyjnych przekazanych przez Administratora podczas zbierania danych osobowych informacją, którą Klient powinien się kierować jest przekazana mu w ramach wspominanych klauzul informacyjnych.
1. Kto jest Administratorem Twoich Danych ?
Administratorem Twoich danych osobowych jest firma Przychodnia dla Zwierząt Załoga Czworonoga s.c., e-mail: napisz@przychodniazaloga.pl, telefon 605-455-782, ul. Pomorska 96, 91-402 Łódź (dalej : Administrator)
2. Jak dbamy o Twoje dane osobowe ?
Dane osobowe każdego z naszych Klientów są przetwarzane zgodnie z Rozporządzeniem Parlamentu Europejskiego i Rady (UE) 2016/679 z dnia 27 kwietnia 2016 r. w sprawie ochrony osób fizycznych w związku z przetwarzaniem danych osobowych i w sprawie swobodnego przepływu takich danych oraz uchylenia dyrektywy 95/46/WE (Dz.Urz.UE.L Nr 119, str. 1) (dalej : „RODO”) oraz innymi aktualnie obowiązującymi przepisami, tj. przez cały okres przetwarzania określonych danych, przepisami prawa o ochronie danych osobowych.
Dane osobowe oznaczają informacje o zidentyfikowanej lub możliwej do zidentyfikowania osobie fizycznej (zwane dalej: „Danymi Osobowymi”). Możliwa do zidentyfikowania osoba fizyczna to osoba, którą można bezpośrednio lub pośrednio zidentyfikować, w szczególności na podstawie identyfikatora takiego jak imię i nazwisko, numer identyfikacyjny, dane o lokalizacji, identyfikator internetowy lub jeden bądź kilka szczególnych czynników określających fizyczną, fizjologiczną, genetyczną, psychiczną, ekonomiczną, kulturową lub społeczną tożsamość osoby fizycznej.
Administrator dokłada szczególnej staranności w celu ochrony interesów osób, których dane dotyczą, a w szczególności zapewnia, że zbierane przez niego dane są:
przetwarzane zgodnie z prawem, rzetelnie i w sposób przejrzysty dla osoby, której dane dotyczą;
zbierane w konkretnych, wyraźnych i prawnie uzasadnionych celach i nieprzetwarzane dalej w sposób niezgodny z tymi celami;
adekwatne, stosowne oraz ograniczone do tego, co niezbędne do celów, w których są przetwarzane;
prawidłowe i w razie potrzeby uaktualniane;
przechowywane w formie umożliwiającej identyfikację osoby, której dane dotyczą, przez okres nie dłuższy, niż jest to niezbędne do celów, w których dane te są przetwarzane;
przetwarzane w sposób zapewniający odpowiednie bezpieczeństwo Danych Osobowych, w tym ochronę przed niedozwolonym lub niezgodnym z prawem przetwarzaniem oraz przypadkową utratą, zniszczeniem lub uszkodzeniem, za pomocą odpowiednich środków technicznych lub organizacyjnych.
3. W jakich celach informacje o Tobie są przez nas przetwarzane?
Każdorazowo cel i zakres danych przetwarzanych przez Administratora wynikają ze zgody Klienta lub przepisów prawa oraz doprecyzowywane są w wyniku działań podejmowanych przez Klienta na naszej stronie internetowej.
Dane Osobowe Klientów przetwarzane są przez Administratora w szczególności w celu świadczenie usług weterynaryjnych, ponadto może się zdarzyć że będą przetwarzane w celach statystycznych czy też w innych celach służących wypełnieniu obowiązków prawnych wynikających z obowiązujących przepisów prawa
4. Z jakich Twoich danych korzystamy ?
Administrator może przetwarzać w szczególności następujące Dane Osobowe Klientów:
Dane Osobowe podane w formularzu kontaktowym na stronie internetowej przychodni prowadzonej przez Administratora (w szczególności: imię i nazwisko; adres poczty elektronicznej; numer telefonu kontaktowego; adres [ulica, numer domu, numer lokalu, kod pocztowy, miejscowość, kraj],
Dane Osobowe podane podczas pierwszej wizyty służące założeniu karty Klienta i umożliwiające na prawidłowe świadczenie usługi weterynaryjnej (imię i nazwisko,; adres poczty elektronicznej; numer telefonu kontaktowego; adres [ulica, numer domu, numer lokalu, kod pocztowy, miejscowość, kraj), imię zwierzęcia, nr rachunku bankowego., PESEL).
5. Czy podanie Twoich danych ma charakter obowiązkowy?
Podanie Danych Osobowych przez Klienta jest dobrowolne, jednak jest konieczne do skorzystania z usług świadczonych przez Administratora czy też umówienia spotkania w przychodni.
6. Na jakiej podstawie prawnej korzystamy z informacji o Tobie?
Podstawą przetwarzania Danych Osobowych Klienta jest przede wszystkim konieczność wykonania umowy (świadczenia usługi weterynaryjnej), której jest stroną lub konieczność podjęcia na jego żądanie działań przed jej zawarciem (art. 6 ust. 1 lit. b) RODO).
Dotyczy to przede wszystkim Danych Osobowych podawanych w formularzu kontaktowym na stronie internetowej Administratora czy też podczas wizyty w przychodni.
W pozostałych (innych) celach Dane Osobowe Klienta mogą być przetwarzane na podstawie:
obowiązujących przepisów prawa – gdy przetwarzanie jest niezbędne do wypełnienia obowiązku prawnego ciążącego na Administratorze, np. gdy na bazie przepisów podatkowych lub rachunkowych Administrator rozlicza zawarte umowy sprzedaży (art. 6 ust. 1 lit. c) RODO);
niezbędności do innych niż wymienione powyżej celów wynikających z prawnie uzasadnionych interesów realizowanych przez Administratora lub przez stronę trzecią, w szczególności do ustalenia, dochodzenia lub obrony roszczeń, prowadzenia korespondencji z Klientami, także za pośrednictwem formularzy kontaktowych (w tym udzielania odpowiedzi na wiadomości Klientów) (art. 6 ust. 1 lit. f) RODO).
7. Czy Twoje Dane Osobowe podlegają profilowaniu ?
Nie, Administrator nie profiluje Twoich Danych Osobowych
8. Czy i komu możemy przekazywać Twoje Dane Osobowe ?
W przetwarzaniu Danych Osobowych w ograniczonym zakresie mogą brać udział partnerzy Administratora, w szczególności Ci którzy technicznie pomagają sprawnie prowadzić stronę internetową Administratora, dostawcy usług hostingu lub usług teleinformatycznych, podmioty obsługujące płatności elektroniczne, jak również dostawcy usług prawnych i doradczych.
9. Czy Twoje Dane mogą być przekazywane do państw trzecich? (spoza Europejskiego Obszaru Gospodarczego)
Dane osobowe Klientów nie są przekazywane do państw trzecich. W odniesieniu do danych Klientów, Administrator nie korzysta też z narzędzi służących wspieraniu bieżącej działalności, a które umożliwiałyby przekazywanie danych osobowych Klientów poza granice Europejskiego Obszaru Gospodarczego (np. narzędzi Google.)
10. Jakie prawa Ci przysługują?
Każdemu Klientowi przysługuje w każdym czasie prawo do:
wniesienia skargi do Prezesa Urzędu Ochrony Danych Osobowych;
przenoszenia Danych Osobowych, które dostarczył Administratorowi i które są przetwarzane w sposób zautomatyzowany, a przetwarzanie odbywa się na podstawie zgody lub na podstawie umowy, np. do innego administratora;
dostępu do Danych Osobowych (w tym np. otrzymania informacji, które Dane Osobowe są przetwarzane);
żądania sprostowania i ograniczenia przetwarzania (np. jeśli Dane Osobowe są nieprawidłowe) lub usunięcia Danych Osobowych (np. w przypadku, gdy były one przetwarzane niezgodnie z prawem);
cofnięcia każdej wyrażonej Administratorowi zgody (o ile była udzielona) w dowolnym momencie, przy czym cofnięcie zgody nie wpływa na przetwarzanie dokonywane przez Administratora zgodnie z prawem przed jej cofnięciem.
wniesienia sprzeciwu wobec przetwarzania dotyczących go Danych Osobowych dokonywanego w celu realizacji prawnie uzasadnionych interesów Administratora lub strony trzeciej, w tym w szczególności wobec przetwarzania na potrzeby marketingu.
11. Przez jaki okres będziemy przechowywali Twoje Dane Osobowe?
Dane Osobowe mogą być przechowywane nie dłużej niż jest to wymagane do procesu realizacji świadczonych usług przez Administratora. Dane osobowe są przechowywane w bazie danych, w której zastosowano środki techniczne i organizacyjne zapewniające należytą ochronę przetwarzanych danych.
Jeżeli przetwarzanie Danych Osobowych jest uzależnione od zgody Klienta, Dane Osobowe mogą być przetwarzane dopóki nie zostanie ona cofnięta.
Jednocześnie, w każdym przypadku:
Dane Osobowe będą przechowywane również wtedy, gdy przepisy prawa (np. księgowe lub podatkowe) będą zobowiązywać Administratora do ich przetwarzania;
Dane Osobowe będziemy przechowywać dłużej na wypadek, gdyby Klient miał wobec Administratora jakiekolwiek roszczenia, w celu dochodzenia roszczeń przez Administratora, bądź w celu dochodzenia lub obrony przed roszczeniami osób trzecich, przez okres ich przedawnienia określony przepisami prawa, w szczególności kodeksu cywilnego.
W zależności od zakresu Danych Osobowych i celów ich przetwarzania mogą być więc one przechowywane przez różny okres.
W każdym przypadku decyduje dłuższy termin przechowywania Danych Osobowych.
12. Administrator informuje też, że wykorzystuje pliki cookies, czyli krótkie pliki tekstowe, zawierające informacje, zapisywane w systemie informatycznym Klienta na urządzeniu końcowym, z którego dokonano połączenia ze stroną internetową Administratora. Pliki te pozwalają na późniejszą identyfikację Klienta w razie ponownego połączenia Klientaz urządzenia końcowego, na którym zostały zapisane. Klient ma prawo w każdym czasie wyłączyć cookies.
13. Jeżeli masz jakiekolwiek pytania, możesz się z nami skontaktować :
mailowo : napisz@przychodniazaloga.pl
pisemnie na adres : ul. Pomorska 96, 91-402 Łódź, NIP : 7252312895
14. Administrator zastrzega sobie prawo do aktualizacji lub wprowadzania zmian w niniejszej Polityce Prywatności.